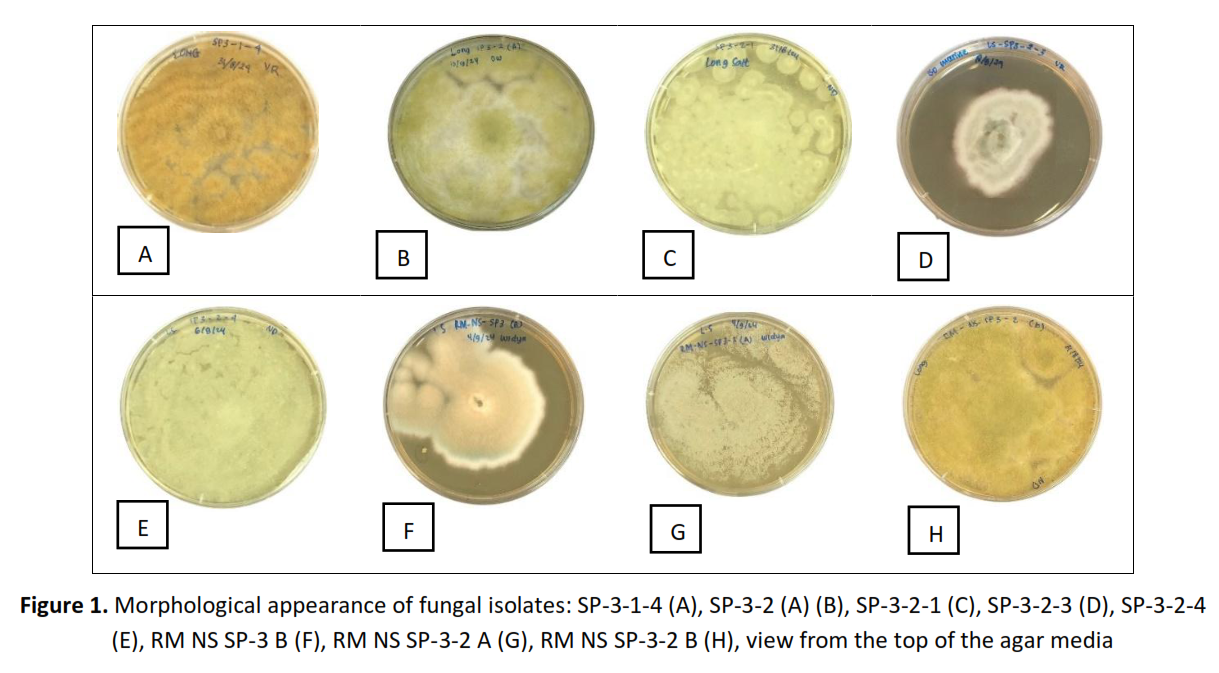

Antimicrobial and Antioxidant Properties of Marine Fungi Associated with the Sponge Pseudoceratina sp. from Amed Coastal Waters, Bali, Indonesia
DOI:
https://doi.org/10.36733/medicamento.v12i1.13356Keywords:
antimicrobial, antioxidant, marine fungi, marine sponges, Pseudoceratina, toxicityAbstract
Background: Marine fungi are organisms capable of growth and spore production in the marine environment and establishing symbiotic relationships with other marine organisms. Because of their high biochemical diversity, marine fungi are considered a potential source for the discovery of new natural compounds with various biological activities.
Objective: This study aims to conduct molecular identification and assess the bioactivity potential of the methanol extract obtained from endophytic fungi associated with the marine sponge Pseudoceratina sp. from the Amed Coastal Waters, Bali.
Methods: Eight marine fungi were isolated in this study and identified through molecular biology protocol as Aspergillus tamarii SP-3-1-4, Aspergillus nomiae SP-3-2 (A), Penicillium citrinum SP-3-2-1, Aspergillus protuberus SP-3-2-3, Aspergillus sydowii SP-3-2-4, Aspergillus sydowii RM NS SP-3B, Aspergillus clavatonanicus RM NS SP-3-2 A, and Aspergillus nomiae RM NS SP-3-2 B. The fungi were subsequently fermented on rice media containing salt and/or without salt. In the final stage of fermentation, secondary metabolites were extracted using ethyl acetate, followed by liquid-liquid extraction using methanol containing 10% water and n-hexane. The resulting methanolic extracts were subjected to phytochemical analysis and bioassays.
Results: The phytochemical screening results of the methanol extracts showed that all extracts contained alkaloids. Among the tested extracts, the extract obtained from the fermentation of the fungus A. protuberus SP-3-2-3 on rice medium with the addition of salt showed the highest activity against Methicillin-resistant Staphylococcus aureus ATCC 3351 with an inhibition zone diameter of 7.99±0.20 mm. The fungus A. sydowii SP-3-2-4 cultured with and without salt in rice media exhibited the most potent antioxidant capacity, with IC50 values of 37.02±1.12 and 32.48±0.81 µg/mL. Conversely, A. nomiae SP-3-2 (A), fermented without salt, displayed the highest toxicity with an LC50 value of 0.88±0.69 µg/mL.
Conclusion: Based on the pharmacological potential of extracts produced by the marine fungi associated with the sponge Pseudoceratina sp. found in the present study, identification of bioactive secondary metabolites and their mode of action is propitious for further investigation.
References
1. Lopez-Moya F, Barretta R, Gonçalves MFM, Esteves AC, Alves A. Marine Fungi: Opportunities and challenges. Encyclopedia. 2022;2(1):559-577. doi:10.3390/encyclopedia2010037
2. Wang Z, Qader M, Wang Y, Kong F, Wang Q, Wang C. Progress in the discovery of new bioactive substances from deep-sea associated fungi during 2020-2022. Front Mar Sci. 2023;10:1232891. doi:10.3389/fmars.2023.1232891
3. Barzkar N, Sukhikh S, Babich O. A comprehensive review of marine sponge metabolites, with emphasis on Neopetrosia sp. Int J Biol Macromol. 2024;280(Pt 2). doi:10.1016/j.ijbiomac.2024.135823
4. Yuan Y, Lei Y, Xu M, Zhao B, Xu S. Bioactive terpenes from marine sponges and their associated organisms. Mar Drugs. 2025;23(3):96. doi:10.3390/md23030096
5. Kurimoto SI, Inoue K, Ohno K, Kubota T. Ceratinadin G, A new psammaplysin derivative possessing a cyano group from a sponge of the genus Pseudoceratina. J Org Chem. 2024; 20(1): 3215-3220.doi:10.3762/bjoc.20.267
6. Mohamed HM, Murshid SSA, Alreemi RM, Alyahyawy OY, Mohamed GA, Ibrahim SRM. The genus Pseudoceratina: phytochemistry, biosynthesis, and pharmacology. Results Chem. 2025;18(7):102714. doi:10.1016/j.rechem.2025.102714
7. Ueda JY, Takagi M, Shin-Ya K. New xanthoquinodin-like compounds, JBIR-97, -98 and-99, obtained from marine sponge-derived fungus Tritirachium sp. SpB081112MEf2. J Antibiot. 2010;63(10):615-618. doi:10.1038/ja.2010.92
8. Gonçalves MFM, Paço A, Escada LF, Albuquerque MSF, Pinto CA, Saraiva J, Duarte AS, Rocha-Santos TAP, Esteves AC, Alves A. Unveiling biological activities of marine fungi: The effect of sea salt. Appl Sci. 2021;11(13). doi:10.3390/app11136008
9. Esmeralda M, Ngedo E, Tria K, Dewi N, Putu N, Leliqia E, Ariantari P. Uji toksisitas ekstrak metanol jamur yang diisolasi dari spons Phyllospongia foliascens menggunakan metode Brine Shrimp Lethality Test (BSLT). J PharmUdayana. 2025;14(1):41-50. doi:10.24843/JFU.2025.v14.i01.p08
10. Wulandari NMW, Dwijayanti NK, Putri NPAE, Putra IPYA, Leliqia NPE, Wibowo JT, Dwija IBNP, Ariantari NP. Bioactivities and molecular identification from marine sediment-derived fungi isolated from Amed and Tulamben Beaches. J Ilm Medicam. 2025;11(1):74-85. doi:10.36733/medicamento.v11i1.10745
11. Ariantari NP, Putra IPYA, Leliqia NPE, Yustiantara PS, Proborini MW, Nugraheni N, Zulfin UM, Jenie RI, Meiyanto E. Antibacterial and cytotoxic secondary metabolites from endophytic fungi associated with Antidesma bunius leaves. J Appl Pharm Sci. 2023;13(7):132-143. doi:10.7324/JAPS.2023.101347
12. Putra IPYA, Ariantari NP, Wibowo JT, Leliqia NPE, Dwija IBNP, Wulandari NMW, Dwijayanti NK, Putri NPAE, Dewi KTN. Phyllospongia foliascens-derived fungi: molecular identification, antimicrobial activity and secondary metabolite profile of their methanolic extracts. In: BIO Web of Conferences. Vol 176. EDP Sciences; 2025. doi:10.1051/bioconf/202517602003
13. Putra IPYA, Utami KS, Hardini J, Wirasuta IMAG, Ujam NT, Ariantari NP. Fermentation, bioactivity and molecular identification of endophytic fungi isolated from mangrove Ceriops tagal. Biodiversitas. 2023;24(5):3091-3098. doi:10.13057/biodiv/d240565
14. Ariantari NP, Leliqia NPE, Putra IPYA, Nugraheni N, Jenie RI, Meiyanto E. Endophytic fungi from red ginger (Zingiber officinale var. rubrum) as promising source of antimicrobial and cytotoxic secondary metabolites. J Appl Pharm Sci. 2024;14(11):100-110. doi:10.7324/JAPS.2024.178823
15. Dubale S, Kebebe D, Zeynudin A, Abdissa N, Suleman S. Phytochemical screening and antimicrobial activity evaluation of selected medicinal plants in Ethiopia. J Exp Pharmacol. 2023;15(1):51-62. doi:10.2147/JEP.S379805
16. Maheshwaran L, Nadarajah L, Senadeera SPNN, Ranaweera CB, Chandana AK, Pathirana RN. Phytochemical testing methodologies and principles for preliminary screening/qualitative testing. J Asian Plant. 2024;12(5):11-38. doi:10.9734/aprj/2024/v12i5267
17. Iqbal M, Jariah AA. Phytochemical screening of secondary metabolite compounds in tammate leaf extract (Lannea coromandelica (HOUTT.) MERR.) from Pangkep Regency using various extraction methods. J Health Science. 2025;5(1):59-66. doi:10.47679/jchs.2025107
18. Godlewska K, Pacyga P, Najda A, Michalak I. Investigation of chemical constituents and antioxidant activity of biologically active plant-derived natural products. Molecules. 2023;28(14):1-77. doi:10.3390/molecules28145572
19. Hoang TNN, Phan TT, Phan TKL, Nguyen NHV, Dong TAD, Le THA. Phytochemical screening, extraction, and determination of the bioactivities of the extract-enriched polyphenols and saponins from Musa balbisiana Fruit. J Food Process Preserv. 2023;2023. doi:10.1155/2023/2581641
20. Walker RD. Standards for Antimicrobial Susceptibility Testing. Vol 60. 1999.
21. Ariantari NP, Putra IPYA, Dwiyani NMW, Leliqia NPE, Wirajana IN, Yustiantara PS, Febriansah R. Antimicrobial, cytotoxicity, and LC-MS/MS analysis of methanolic extract of Fusarium proliferatum ZO-L2-4, an endophytic fungus isolated from Zingiber officinale Roscoe. J Pharm Pharmacogn Res. 2025;13(1):152-162. doi:10.56499/jppres23.1899_13.1.152
22. Gajic I, Kabic J, Kekic D, Jovicevic M, Milenkovic M, Mitic Culafic D, Trudic A, Ranin L, Opavski N. Antimicrobial susceptibility testing: a comprehensive review of currently used methods. Antibiotics. 2022;11(4):1-26. doi:10.3390/antibiotics11040427
23. Baliyan S, Mukherjee R, Priyadarshini A, Vibhuti A, Gupta A, Pandey RP, Chang CM. Determination of antioxidants by DPPH radical scavenging activity and quantitative phytochemical analysis of Ficus religiosa. Molecules. 2022;27(4). doi:10.3390/molecules27041326
24. Nugraheni TS, Setiawan I, Putri AA, Sukmawati AW, Khasanah LN, Nisa LK, Putri LNH, Wulandari SK, Riswana SA. Tinjauan artikel: macam-macam metode pengujian aktivitas antioksidan. J Pharm. 2023;13(1):2656-8950. doi:10.51601/ijhp.v5i1.407
25. Ariantari NP, Putra IPYA, Wibowo JT, Putri SAMDA, Nabila CIB, Kristiani NKA, Wirasuta IMAG. Evaluation of antibacterial and toxicity properties of marine endophytic fungi from red algae Gracilaria salicornia and Chondrus sp. BIO Web Conf. 2024;92:1-12. doi:10.1051/bioconf/20249202019
26. Nerdy N, Lestari P, Sinaga JP, Ginting S, Zebua NF, Mierza V, Bakri TK. Brine shrimp (Artemia salina leach.) lethality test of ethanolic extract from green betel (Piper betle linn.) and red betel (Piper crocatum ruiz and pav.) through the soxhletation method for cytotoxicity test. Open Access Maced J Med Sci. 2021;9:407-412. doi:10.3889/oamjms.2021.6171
27. Fithrotunnisa Q, Arsianti A, Kurniawan G, Qorina F, Tejaputri NA, Azizah NN. In vitro cytotoxicity of Hibiscus sabdariffa Linn extracts on A549 lung cancer cell line. Phcog J. 2020;12(1):14-19. doi:10.5530/pj.2020.12.3
28. Hasbi N, Rosyunita R, Rahim AR, Wardoyo EH, Arnawati IA, Haza SS, Hulfifa LN, Alamsyah ADCF, Validika IKS. Phytochemical screening and antibacterial activity test of sumbawa white honey against Bacillus megaterium. J Scientis. 2023;9(10):8707-8712. doi:10.29303/jppipa.v9i10.4913
29. Viotti C, Chalot M, Kennedy PG, Maillard F, Santoni S, Blaudez D, Bertheau C. Primer pairs, PCR conditions, and peptide nucleic acid clamps affect fungal diversity assessment from plant root tissues. Mycology. 2024;15(2):255-271. doi:10.1080/21501203.2023.2301003
30. Handayani D, Dwinatrana K, Rustini R. Antibacterial compound from marine spone derived fungus Aspergillus sydowii DC08. Rasayan J Chem. 2022;15(4):2485-2492. doi:10.31788/RJC.2022.1546971
31. Artasasta MA, Yanwirasti Y, Taher M, Djamaan A, Ariantari NP, Edrada-Ebel RA, Handayani D. Apoptotic activity of new oxisterigmatocystin derivatives from the marine-derived fungus Aspergillus nomius NC06. Mar Drugs. 2021;19(11):1-10. doi:10.3390/md19110631
32. Sabdaningsih A, Liu Y, Mettal U, Heep J, Riyanti, Wang L, Cristianawati O, Nuryadi H, Sibero MT, Marner M, Radjasa OK, Sabdono A, Trianto A. A new citrinin derivative from the Indonesian marine sponge-associated fungus Penicillium citrinum. Mar Drugs. 2020;18(227):1-12.
33. Grillo G, Capaldi G, Radošević K, Jakopović Ž, Markov K, Brncic M, Gallina L, Calcio Gaudino E, Cravotto G. Unlocking the bioactive potential of pomegranate peels: A green extraction approach. Antioxidants. 2023;12(10). doi:10.3390/antiox12101796
34. Sander A, Petračić A, Rogošić M, Župan M, Frljak L, Cvetnić M. Feasibility of different methods for separating n-hexane and ethanol. Separations. 2024;11(5). doi:10.3390/separations11050151
35. Said G, Ahmad F. Effects of salt concentration on the production of cytotoxic geodin from marine-derived fungus Aspergillus sp. Turk J Biochem. 2022;47(4):399-402. doi:10.1515/tjb-2022-0058
36. Ibrahim SRM, Mohamed SGA, Alsaadi BH, Althubyani MM, Awari ZI, Hussein HGA, Aljohani AA, Albasri JF, Faraj SA, Mohamed GA. Secondary metabolites, biological activities, and industrial and biotechnological importance of Aspergillus sydowii. Mar Drugs. 2023;21(8). doi:10.3390/md21080441
37. Gu Y, Ding P, Liang Z, Song Y, Liu Y, Chen G, Li JL. Activated production of silent metabolites from marine-derived fungus Penicillium citrinum. Fitoterapia. 2018;127(2):207-211. doi:10.1016/j.fitote.2018.02.012
38. Salazar-Alekseyeva K, Herndl GJ, Baltar F. Influence of salinity on the extracellular enzymatic activities of marine pelagic fungi. J Fungi. 2024;10(2). doi:10.3390/jof10020152
39. Behera AD, Das S. Ecological Insights and Potential Application of Marine Filamentous Fungi in Environmental Restoration. Vol 22. Springer Netherlands; 2023. doi:10.1007/s11157-023-09655-2
40. Ogbole OO, Adebayo-Tayo BC, Salawu KM, Okoli VC. Molecular Identification and antimicrobial activity of endophytic fungi Aspergillus tamarii (Trichomaceae). Nig Journ Pharm Sci. 2017;16(1):41-48. doi:10.24843/JNP.2017.v16.i01.p41
41. Ashoka GB, Shivanna MB. Antibacterial, antioxidant, and anticancer activities of Penicillium citrinum Thom. endophytic in Jatropha heynei. J Appl Pharm Sci. 2023;13(3):196-207. doi:10.7324/JAPS.2023.95958
42. Isah T, Umar S, Mujib A, Sharma MP, Rajasekharan PE, Zafar N, Frukh A. Secondary metabolism of pharmaceuticals in the plant in vitro cultures: strategies, approaches, and limitations to achieving higher yield. Plant Cell Tissue Organ Cult. 2018;132(2):239-265. doi:10.1007/s11240-017-1332-2
43. Hu X, Li X, Meng L, Wang B. Antioxidant bisabolane-type sesquiterpenoids from algal-derived fungus Aspergillus sydowii EN-434. J Oceanol Limnol. 2020;38(5):1532-1536. doi:10.1007/s00343-020-0049-y
44. Samanthi KAU, Wickramarachchi S, Wijeratne EMK, Paranagama PA. Two new bioactive polyketides from Curvularia trifolii, an endolichenic fungus isolated from Usnea sp., in Sri Lanka. J Natl Sci Found. 2015;43(3):217-224. doi:10.4038/jnsfsr.v43i3.7950
45. Endra P, Ricka I. Aktivitas antioksidan fraksi etil asetat dan air ranting buah parijoto (Medinilla speciosa Blume) dengan perendaman radikal bebas DPPH. J Pharm Cend. 2021;5(2):135-144. doi:doi.org/10.31596/cjp.v5i2.143
46. Wulandari S, Okta FN, Utami SP, Giovani SDC. Uji toksisitas ekstrak etil asetat biji kebiul (Caesalpinia bonduc L.) pada ekstraksi maserasi. J I Phar. 2024;11(2):32-46. doi:10.52161/jiphar.v11i2.590
47. Ismail MA, Vitayani S, Aulia N, Mangarengi Y, Karim M. Cytotoxicity test of Green betel leaf ethanol extract (Piper betle L .) using shrimp larvae (Artemia salina L .) using the Brine Shrimp Lethality Test (BSLT) method. J Health Pharm. 2025;5(1):138-149. doi:doi.org/10.51601/ijhp.v5i1.407
48. Handayani D, Artasasta MA, Mutia D, Atikah N, Rustini, Tallei TE. Antimicrobial and cytotoxic activities screening of fungal secondary metabolites isolated from marine sponge Callyspongia sp. AACL Bioflux. 2021;14(1):249-258. doi:doi.org/10.31596/cjp.v5i2.143
49. Khasanah NW, Karyadi B, Sundaryono A. Phytochemical test and toxicity of Hydnophytum sp. against Artemia salina Leach. J Science Edu. 2020;4(1):47-53. doi:10.33369/pendipa.4.1.47-53
50. Satya NA, Pradana DLC, Kolib A, Aprilia CA. Brine shrimp lethality test on aqueous extract of Caesalpinia Sappan L. JFIOnline. 2021;13(1):62-67. doi:10.35617/jfionline.v13i1.54
51. Wang Y, Lu Z, Sun K, Zhu W. Effects of high salt stress on secondary metabolite production in the marine-derived fungus Spicaria elegans. Mar Drugs. 2011;9(4):535-542. doi:10.3390/md9040535
Downloads
Published
How to Cite
Issue
Section
License
Copyright (c) 2026 I Made Agus Kusuma Adi, Ni Komang Diah Eka Witantri, Ni Made Widya Wulandari, Ni Putu Eka Leliqia, I Nengah Wirajana, Joko Tri Wibowo, Ismail Ware, Ni Putu Ariantari

This work is licensed under a Creative Commons Attribution-NonCommercial-ShareAlike 4.0 International License.





















